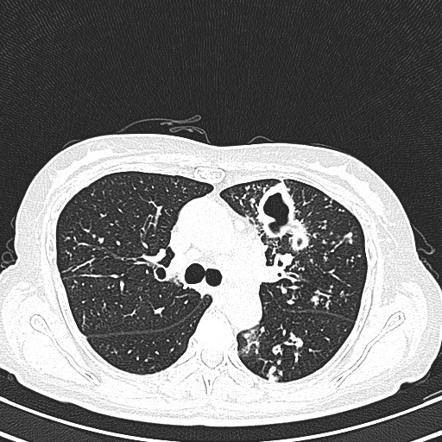
得了肺结核家人怎样预防,家长确诊肺结核对孩子有什么影响

有一个四岁的小男孩,反复咳嗽一个多月,一直在吃中药,效果时好时坏。
好几次别人建议去拍个片,但小孩的妈妈认为只是支气管炎,拍片没必要且有辐射,没有听取别人的意见。
直到有一天,孩子出现发热,才去正规医院就诊并住院治疗。
入院后,小孩检查出有肺结核。

医院每周都有主任医师查房,那天查房时主任医师对家属说:
“肺结核是一种传染病,小孩的肺结核,可能存在两种情况:一种情况是,肺结核有可能是家属传染给小孩;另一种情况是,小孩有肺结核之后,也会传染给家长。
所以,肺结核的亲密接触家属,也需要查一查。”
小孩有三个亲密接触的家属:父亲、母亲和奶奶。父亲、母亲先做检查,没有问题。奶奶一开始有点不太情愿,主管医生费了好大的劲说服她,才去做了检查。
结果发现,奶奶的双肺都有结核病灶,且有空洞形成,病情比小孩严重多了。
考虑小孩的肺结核,是奶奶传染给他的。但是,奶奶除了偶尔咳嗽和盗汗之外,并没有其他的症状。
这个真实的临床案例说明,有传染性的肺结核,可能隐藏在人们的周围。
今天,就来科普一下如何远离肺结核?
结核是怎么传播的?
结核病是由结核分枝杆菌引起的感染性疾病,我们最常接触到的是肺结核和结核性胸膜炎(也就是“胸腔积水”),这是国家的法定乙类传染病。
肺结核属于呼吸道传染病,人与人之间结核分枝杆菌的传播,主要是通过吸入带有这个细菌的飞沫而实现的。
这种飞沫多半是在肺结核患者咳嗽、打喷嚏、唱歌、大声说话的时候产生的。产生的飞沫有大有小:比较大的飞沫由于重力的作用,可能会很快坠落到地上;小的飞沫,比如直径在1~5微米之间的飞沫,会漂浮在空气中,通过吸入而感染。
这个主要是因为含有结核分析杆菌的飞沫吸入以后,必须要到达肺泡或者附近,才有可能引发感染。而要到达肺泡,则必须要经过直径在5微米以下的呼吸性细支气管。大于这个直径的飞沫会被阻挡,而后通过气管和支气管表面的纤毛,像扫地一样,由内而外慢慢“扫”出来。
被“扫”出来的飞沫和其他微尘,被呼吸道分泌的黏液黏附和包裹,再像“滚雪球”一样,黏液团越滚越大,最终形成痰液,又重新吐回到外界环境中。

找出具有传染性的结核患者
要预防结核分枝杆菌经吸入而感染,先得识别哪些人能够通过这种方式排菌,找出他们并予以隔离和治疗,从而避免传染给他人。
以下是具有传染性的结核患者:
- 活动性肺结核,或者喉结核的患者,没有经过治疗的。
- 空洞型肺结核,也就是肺结核的病灶,看上去就像肺上“烂”了个“洞”。由于病灶中有被结核杆菌破坏的组织,坏死物质沿着支气管、气管排出体外后,就留下了空洞,坏死组织里面结核分枝杆菌的浓度是很高的。
- 痰涂片,也叫抗酸杆菌涂片,呈现阳性的人。
- 痰液结核分枝杆菌复合体核酸扩增试验(TB-DNA)阳性者。
- 痰培养出结核分枝杆菌(阳性)者,尤其是在9天之内就培养出阳性的人,其传染性更强。
以上情况既可以单独存在,也可以好几种情况都存在,分开列出来是为了让大家提高警惕。

一些医疗操作有风险
有时候,在做某些操作和治疗的时候,会增加结核分枝杆菌传播的风险。比如,做气管插管、支气管镜检查,或者做胸部的物理治疗、使用药物雾化吸入治疗,以及结核性脓肿的灌洗治疗时,等等。
不过,并非有结核一定会传染。
如果仅仅是肺以外的某些地方,比如关节、皮肤、肾、肝等部位的结核,属于单独的病灶,没有肺结核和喉结核的,通常不具有传染性,不通过呼吸道传染。

预防的措施
结核在国内是一种非常普遍的疾病,特别是没有治疗的肺结核患者,由于没有明确的症状,很容易被人忽略,在人群中造成隐蔽的传播。
家中或者生活、工作的环境,如果发现有肺结核患者,为了做好预防,必须采取以下的一些措施:
1、开放性肺结核患者,也就是说在痰液中能够找到或者培养出结核分枝杆菌的人,要有一段时间必要的隔离,最好在定点医院住院治疗一段时间。通过抗结核治疗,杀死一部分增殖活跃的细菌,是阻止传播的非常关键的措施。
2、对于患者本人,要注意佩戴医用外科口罩,在某些情况下,如果没有戴口罩,则应该在咳嗽、打喷嚏的时候,尽量用纸巾捂住口鼻,或者贴近地面咳嗽或打喷嚏,以避免飞沫在空中飘散。
3.在患者传染性很厉害的情况下,家属应该尽量避免探视,必须要探视的情况下,应戴好口罩。
事实上,外科口罩在预防肺结核方面作用不是很大,专业医务人员或者密切接触者在传染性很强的时候,应该戴N95口罩,且需要正确的佩戴,保持良好的气密性,以确保口罩与面部达到最佳的贴合,才能发挥预防作用。
4.在不知情的情况下,接触了传染性的肺结核患者时,应该怎么办呢?应该及时、定期接受检查,以发现被传播的可能。

接触过结核患者,应该怎么办?
对于肺结核的密切接触者,应该去结核病防治机构或者综合医院的传染科、感染科门诊就诊。
- 仔细回忆症状,比如说有没有发热、咳嗽、盗汗、食欲不振、体重下降等表现。
- PPD试验和结核感染T淋巴细胞试验,又叫T-SPOT检查,是比较常用的检查。
- 如果以上检查阳性,则需要进一步的做胸部X线或肺部CT的检查;如果阴性,可在两个月至两个半月内复查,没问题基本可以排除。

哪些人具有得肺结核的风险?
对于有一些疑似活动性肺结核的患者,要评估是不是有肺结核的可能,有以下情况的时候,要引起注意:
- 出生于或者旅行到结核流行的地区,与已知有传染性的肺结核患者有密切接触的人。
- PPD试验或者T-SPOT阳性者。
- 咳嗽持续2~3周,且至少还存在一种其他症状者,包括发热、盗汗、食欲不振、体重减轻、咳血,等等。
- 感染HIV,或者有不明原因的咳嗽和发热者。
- 一开始考虑社区获得性肺炎,经过7~14天的治疗,仍然没有好转者。
- 胸部X线或者CT发现肺结核可能,即使没有症状也应该高度怀疑。
- 使用过违禁药物,比如吸毒者;或者在一些高风险人群聚集的环境下,有居住史者,比如收容所和监狱看守所;或者,这些场所的员工。
- 低收入人群,呼吸系统症状持续2~3周以上者。

肺结核的风险因素
有肺结核风险因素的人,如果同时还有一些基础性的疾病,也是要特别引起注意的,必须要对这些疾病进行积极治疗,以控制病情。
HIV感染者糖尿病患者使用肿瘤坏死因子α拮抗剂等生物制剂进行免疫抑制治疗的人慢性肾衰竭,或者正在做透析治疗的人血液系统的恶性肿瘤患者头颈部的恶性肿瘤患者体重比理想体重低10%以上者有长期接触灰尘、粉尘的工作史,或者诊断矽肺等职业病者曾经做过胃切除术或空回肠旁路手术者

个人的保健措施
除了对结核危险因素和基础疾病进行治疗外,个人保健也是很重要的。
1、保持良好的生活习惯:不熬夜,不过度疲劳和进行持续的体力劳动,劳动后要得到充分的休息。
2、戒掉恶习。比如说吸烟、酗酒、吸毒等等,同时要避免被动吸烟,劝阻家人和身边人戒烟。
3、积极锻炼身体。在环境比较恶劣、污染比较严重时,在家中也可以锻炼。空气质量不太好的情况下,适当的使用口罩。
4、加强营养。这可能是所有自我保健方面最重要的一环。临床发现,营养状况良好的人不容易感染结核,多吃蛋白质丰富的食物,蔬菜水果也需要搭配丰富一些。
5、注意饮食卫生,避免喝未消毒处理的牛奶。因为导致结核病的结核分枝杆菌有两种,一种是人结核分枝杆菌,一种是牛结核分枝杆菌。
而其中的牛分枝杆菌,可通过饮用未经充分消毒的牛奶致病,那些热衷于喝“现挤!”牛奶的人要注意,这种牛奶如果没有经过消毒,有可能导致结核感染,特别是容易导致肠结核。
6、疫苗。目前可以用来预防肺结核的疫苗是卡介苗,这是用牛结核分枝杆菌研制的减毒活疫苗。
卡介苗的应用是非常广泛的,自1921年首次应用于人类以来,其接种人数已经超过30亿。
目前,卡介苗主要用于新生儿的常规免疫,成年人已不建议注射,能够保护婴儿和儿童免于感染严重结核病,如结核性脑膜炎和粟粒性结核病。
7、筛查出需要预防性治疗的人群。针对具有潜伏性结核感染证据者,应给予药物抗结核治疗。

龙医生的温馨提醒
肺结核的广泛传播至今仍然无法遏制,主要归结于很多患者未及时被发现。有传染性的肺结核患者不规范治疗,因药物不良反应的影响而放弃治疗的肺结核患者,是重要的传染源。
对于有风险因素的人,每年定期做肺部影像学检查,是发现肺结核的最重要手段之一。不良的生活习惯,比如吸烟,在一定程度上促进了结核的传播。
虽然目前没有更好的疫苗可用,但是对于个人来讲,避免与人密切接触,及时发现身边人是否有结核,以及加强营养和锻炼,依靠自己的免疫力预防结核感染,还是非常重要的手段。
好了,今天的科普就到这里,您看懂了吗?

我是@龙大夫的肝病课堂 ,一位感染科医生。
看肝病,聊感染,答疑、解惑,科普医学知识,在匆忙的临床工作中,体会温暖文字的力量!
如果有什么想说的,请留言、评论、点赞,欢迎收藏并关注!
#健康出行节#
#423头条知识节#